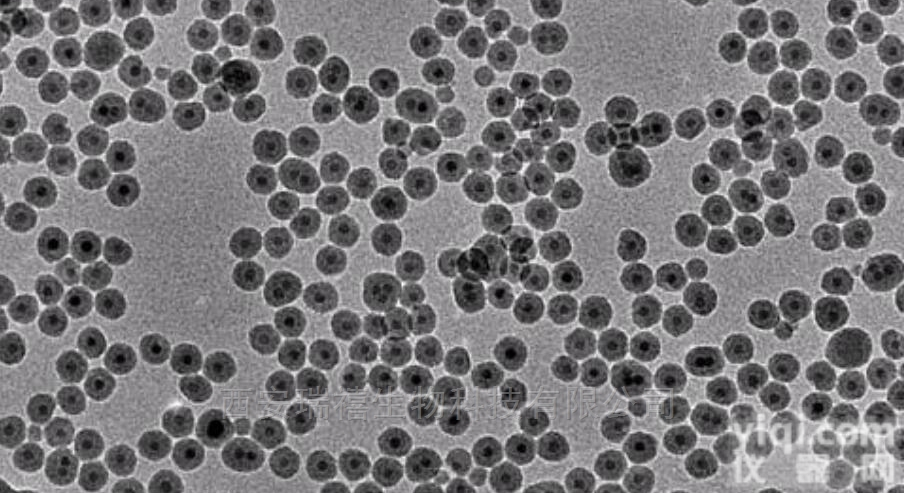
11  2-20nm类球形油溶性<em>纳米</em>银<em>颗粒</em>国产现货

| 新的纳米激光颗粒度仪集成了突破性的技术,使纳米粒子的特性更准确,即使你的样品结块或有一个多峰的粒度分布。这是因为在一个单一的光学测量系统中结合了静态光散射 SLS)和动态光散射(DLS)。这项技术为您提供了Z佳的精度、更好的重复性及覆盖0.6 nm到10um整个尺寸范围更高的分辨率。 | 参量 | 纳米激光颗粒度仪技术参数 | | 粒度范围 | 0.6 nm to 10 μm | | 样品浓度 | Z高到20%(V) | | 重复性 | 优于1% | | 技术 | 静态和动态的多角度激光光散射(SLS&DLS) | | 散射角度 | 10°至 150°,角度分辨率0.01° | | 光源 | 激光@ 638 nm- 15mW | | 样品量 | 3 mL | | 光子计数单位 | 基于PMT的高敏光子计数器 | | 测量时间 | 30s至60s取决于样品和标准 | | 样品设定温度 | 25°C | | 溶剂兼容性 | 玻璃试管用有机溶剂兼容 | | 环境温度 | 10 至 40 °C | | 预热时间 | <3 min | | 尺寸 | W: 341 mm, H: 218 mm, L: 533 mm | | 重量 | 14.5KG | | 软件系统 | Windows 7, Vista, XP 32 & 64位 | | 电脑配置 | Pentium III或相当, RAM 2Go, USB 2 | | 电源 | 115V/60Hz – 230V/50Hz | | 分析软件 NANO EXPERT | 执行用户多角度需求。特色累积量,连续逆算法、针对多峰大小分布测量和聚集检测的多分辨率算法,粒度分布及动力学监测。 | | 通过标准 | 符合CFR21——11, ISO 13320 and 13321 | | 激光安全等级 | 符合EN60825-1/A221 CFR-1040 | | EC标准 | 电磁兼容 : NF EN 61326-1 -2004-108/CEE 电子安全 : NF EN 61010-1 -72.23/CEE | | 附件 | USB 2.0电缆,NanoExpert安装CD-ROM,用户手册 | | 客户关系管理套件 | 定期核查NIST可追踪100纳米乳胶球样本 | |